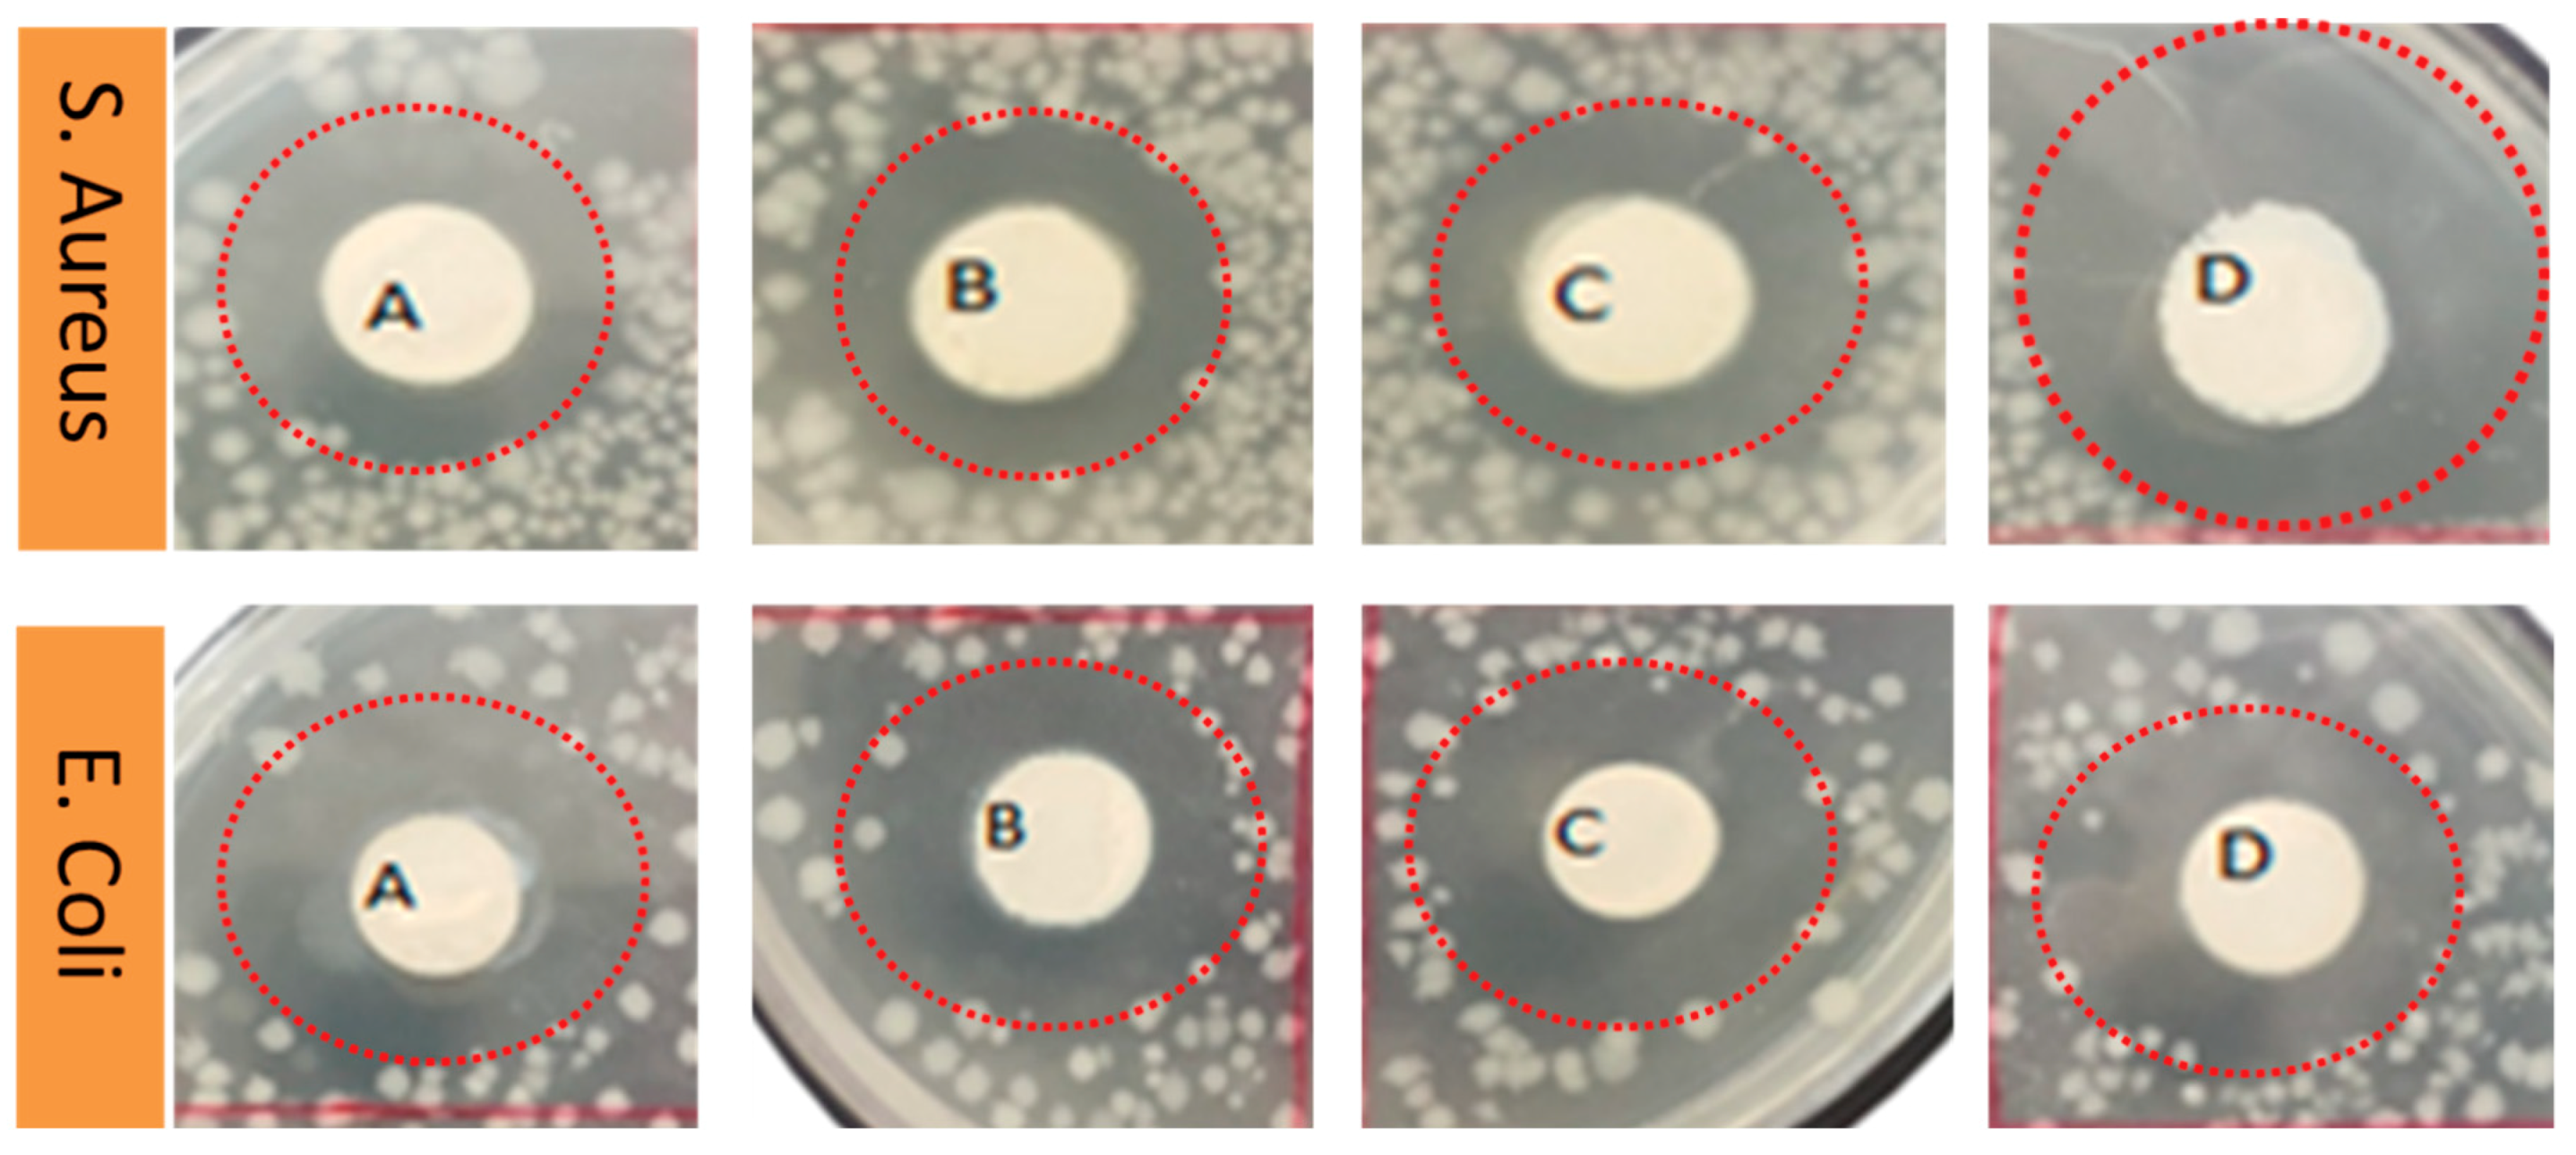
Materials 13 03884 g010 Materials 13 03884 g010

Fabrication of Promising Antimicrobial Aloe Vera/PVA Electrospun Nanofibers for Protective Clothing
Abstract
1. Introduction
2. Materials and Method
2.1. Materials
2.2. Preparation of Aloe Vera and Polyvinyl Alcohol (AV/PVA) Nanofibers
2.3. Characterizations
2.4. Evaluation of Antimicrobial Efficiency
3. Results and Discussion
3.1. Surface Morphology of AV/PVA Electrospun Nanofibers
3.2. FTIR Analysis of AV/PVA Electrospun Nanofibers
3.3. XRD Analysis AV/PVA Electrospun Nanofibers
3.4. Water Contact Angle Analysis
3.5. Release Analysis by ICP
3.6. Degradation Analysis by TGA Study
3.7. Antimicrobial Activity of AV/PVA Electrospun Nanofibers
4. Conclusions
Author Contributions
Funding
Conflicts of Interest
References
- Muñoz-Bonilla, A.; Fernández-García, M. The roadmap of antimicrobial polymeric materials in macromolecular nanotechnology. Eur. Polym. J. 2015, 65, 46–62. [Google Scholar] [CrossRef]
- Hardin, I.R.; Kim, Y. Nanotechnology for Antimicrobial Textiles. In Antimicrobial Textiles; Elsevier: Amsterdam, The Netherlands, 2016; pp. 87–97. [Google Scholar]
- Khan, I.; Saeed, K.; Khan, I. Nanoparticles: Properties, applications and toxicities. Arab. J. Chem. 2019, 12, 908–931. [Google Scholar] [CrossRef]
- Numanoğlu, H.M.; Akgöz, B.; Civalek, Ö. On dynamic analysis of nanorods. Int. J. Eng. Sci. 2018, 130, 33–50. [Google Scholar] [CrossRef]
- Bermúdez-Jiménez, C.; Romney, M.G.; Roa-Flores, S.A.; Martínez-Castañón, G.; Bach, H. Hydrogel-embedded gold nanorods activated by plasmonic photothermy with potent antimicrobial activity. Nanomed. Nanotechnol. 2019, 22, 102093. [Google Scholar] [CrossRef] [PubMed]
- Chaudhary, S.; Kaur, Y.; Jayee, B.; Chaudhary, G.R.; Umar, A. NiO nanodisks: Highly efficient visible-light driven photocatalyst, potential scaffold for seed germination of Vigna Radiata and antibacterial properties. J. Clean. Prod. 2018, 190, 563–576. [Google Scholar] [CrossRef]
- Dresselhaus, M.S.; Black, M.R.; Meunier, V.; Rabin, O. Nanowires. In Springer Handbook of Nanotechnology; Springer: Berlin, Germany, 2017; pp. 249–301. [Google Scholar]
- Thenmozhi, S.; Dharmaraj, N.; Kadirvelu, K.; Kim, H.Y. Electrospun nanofibers: New generation materials for advanced applications. Mater. Sci. Eng. B 2017, 217, 36–48. [Google Scholar] [CrossRef]
- O’Connell, M.J. Carbon Nanotubes Properties and Applications; CRC Press: Cleveland, OH, USA, 2018. [Google Scholar]
- Zhu, J.; Jasper, S.; Zhang, X. Chemical Characterization of Electrospun Nanofibers. In Electrospun Nanofibers; Elsevier: Amsterdam, The Netherlands, 2017; pp. 181–206. [Google Scholar]
- Zhu, J.; Ge, Y.; Jasper, S.; Zhang, X. Physical Characterization of Electrospun Nanofibers. In Electrospun Nanofibers; Elsevier: Amsterdam, The Netherlands, 2017; pp. 207–238. [Google Scholar]
- Ma, J.; Zhang, Q.; Zhang, Y.; Zhou, L.; Yang, J.; Ni, Z. A rapid and simple method to draw polyethylene nanofibers with enhanced thermal conductivity. Appl. Phys. Lett. 2016, 109, 33101. [Google Scholar] [CrossRef]
- Costa, L.; Al-Hashimi, M.; Heeney, M.; Terekhov, A.; Rajput, D.; Hofmeister, W.; Verma, A. Template-synthesis of conjugated Poly(3-Hexylselenophene) (P3HS) nanofibers using femtosecond laser machined fused silica templates. MRS Adv. 2017, 2, 2957–2960. [Google Scholar] [CrossRef]
- Eatemadi, A.; Daraee, H.; Zarghami, N.; Melat Yar, H.; Akbarzadeh, A. Nanofiber: Synthesis and biomedical applications. Artif. Cell Nanomed. B 2016, 44, 111–121. [Google Scholar] [CrossRef]
- Yang, J.; He, F.; Wu, H.; Liang, Y.; Wang, Y.; Sun, Z. Engineering Surface and Optical Properties of TiO2-Coated Electrospun PVDF Nanofibers Via Controllable Self-Assembly. Nanomaterials 2018, 8, 741. [Google Scholar] [CrossRef]
- Agarwal, S.; Wendorff, J.H.; Greiner, A. Use of electrospinning technique for biomedical applications. Polymer 2008, 49, 5603–5621. [Google Scholar] [CrossRef]
- Liu, M.; Duan, X.P.; Li, Y.M.; Yang, D.P.; Long, Y.Z. Electrospun nanofibers for wound healing. Mater. Sci. Eng. 2017, 67, 1413–1423. [Google Scholar] [CrossRef]
- Khan, M.Q.; Kharaghani, D.; Ullah, S.; Waqas, M.; Abbasi, A.M.; Saito, Y.; Zhu, C.; Kim, I.S. Self-cleaning properties of electrospun PVA/TiO2 and PVA/ZnO nanofibers composites. Nanomaterials 2018, 8, 644. [Google Scholar] [CrossRef]
- Fang, J.; Lin, T. Energy Harvesting Properties of Electrospun Nanofibers. In Energy Harvesting Properties of Electrospun Nanofibers; IOP Publishing: Bristol, UK, 2019. [Google Scholar]
- Zhu, R.; Wang, Z.; Cheng, Z.; Kimura, H. Ferroelectric Nanofibers and Their Application in Energy Harvesting. In Nanoscale Ferroelectric-Multiferroic Materials for Energy Harvesting Applications; Elsevier: Amsterdam, The Netherlands, 2019; pp. 181–194. [Google Scholar]
- Hartgerink, J.D.; Beniash, E.; Stupp, S.I. Peptide-amphiphile nanofibers: A versatile scaffold for the preparation of self-assembling materials. Proc. Natl. Acad. Sci. USA 2002, 99, 5133–5138. [Google Scholar] [CrossRef] [PubMed]
- Jiang, R.; Yan, T.; Wang, Y.; Pan, Z. The preparation of PA6/CS-NPs nanofiber filaments with excellent antibacterial activity via a one-step multineedle electrospinning method with liquid bath circling system. J. Appl. Polym. Sci. 2020, 137, 49053. [Google Scholar] [CrossRef]
- Khatri, M.; Hussain, N.; El-Ghazali, E.; Yamamoto, T.; Kobayashi, S.; Khatri, Z.; Ahmed, F.; Kim, I.S. Ultrasonic-assisted dyeing of silk fibroin nanofibers: An energy-efficient coloration at room temperature. Appl. Nanosci. 2020, 10, 917–930. [Google Scholar] [CrossRef]
- Akduman, C.; Kumbasar, E.A. Nanofibers in Face Masks and Respirators to Provide Better Protection. In IOP Conference Series: Materials Science and Engineering; IOP Publishing: Bristol, UK, 2018; Volume 460, p. 012013. [Google Scholar]
- Kalwar, K.; Hu, L.; Li, D.L.; Shan, D. AgNPs incorporated on deacetylated electrospun cellulose nanofibers and their effect on the antimicrobial activity. Polym. Adv. Technol. 2018, 29, 394–400. [Google Scholar] [CrossRef]
- Ahire, J.J.; Hattingh, M.; Neveling, D.P.; Dicks, L.M.T. Copper-Containing Anti-Biofilm Nanofiber Scaffolds as a Wound Dressing Material. PLoS ONE 2016, 11, e0152755. [Google Scholar] [CrossRef] [PubMed]
- Malwal, D.; Gopinath, P. Efficient adsorption and antibacterial properties of electrospun CuO-ZnO composite nanofibers for water remediation. J. Hazard. Mater. 2017, 321, 611–621. [Google Scholar] [CrossRef]
- Liu, X.; Nielsen, L.H.; Kłodzińska, S.N.; Nielsen, H.M.; Qu, H.Y.; Christensen, L.P.; Rantanen, J.; Yang, M.S. Ciprofloxacin-loaded sodium alginate/poly (lactic-co-glycolic acid) electrospun fibrous mats for wound healing. Eur. J. Pharm. Biopharm. 2018, 123, 42–49. [Google Scholar] [CrossRef]
- Han, D.; Sherman, S.; Filocamo, S.; Steckl, A.J. Long-term antimicrobial effect of nisin released from electrospun triaxial fiber membranes. Acta Biomater. 2017, 53, 242–249. [Google Scholar] [CrossRef] [PubMed]
- Sadri, M.; Karimi-Nazari, E.; Hosseini, H.; Emamgholi, A. New chitosan/poly(ethylene oxide)/thyme nanofiber prepared by electrospinning method for antimicrobial wound dressing. J. Nanostruct. 2016, 6, 322–328. [Google Scholar]
- Ho, M.H.; Hsieh, C.C.; Hsiao, S.W.; Hong Thien, D.V. Fabrication of asymmetric chitosan GTR membranes for the treatment of periodontal disease. Carbohyd. Polym. 2010, 79, 955–963. [Google Scholar] [CrossRef]
- Radha, M.H.; Laxmipriya, N.P. Evaluation of biological properties and clinical effectiveness of Aloe vera: A systematic review. J. Tradit. Complement. Med. 2015, 5, 21–26. [Google Scholar] [CrossRef] [PubMed]
- Bozzi, A.; Perrin, C.; Austin, S.; Arce Vera, F. Quality and authenticity of commercial aloe vera gel powders. Food Chem. 2007, 103, 22–30. [Google Scholar] [CrossRef]
- Gentilini, R.; Bozzini, S.; Munarin, F.; Petrini, P.; Visai, L.; Tanzi, M.C. Pectins from Aloe Vera: Extraction and production of gels for regenerative medicine. J. Appl. Polym. Sci. 2014, 131, 39760. [Google Scholar] [CrossRef]
- Salehi, M.; Farzamfar, S.; Bastami, F.; Tajerian, R. Fabrication and characterization of electrospun plla/collagen nanofibrous scaffold coated with chitosan to sustain release of aloe vera gel for skin tissue engineering. Biomed. Eng. Appl. Basis Commun. 2016, 28, 1650035. [Google Scholar] [CrossRef]
- Silva, S.S.; Popa, E.G.; Gomes, M.E.; Cerqueira, M.; Marques, A.P.; Caridade, S.G.; Teixeira, P.; Sousa, C.; Mano, J.F.; Reis, R.L. An investigation of the potential application of chitosan/aloe-based membranes for regenerative medicine. Acta Biomater. 2013, 9, 6790–6797. [Google Scholar] [CrossRef]
- Choi, S.; Chung, M.H. A review on the relationship between aloe vera components and their biologic effects. Semin. Integr. Med. 2003, 1, 53–62. [Google Scholar] [CrossRef]
- Jaganathan, S.; Balaji, A.; Supriyanto, E.; Muhamad, I.I.; Khudzari, A.Z.M. Microwave-assisted fibrous decoration of mPE surface utilizing Aloe vera extract for tissue engineering applications. Int. J. Nanomed. 2015, 10, 5909. [Google Scholar] [CrossRef][Green Version]
- Silva, S.S.; Caridade, S.G.; Mano, J.F.; Reis, R.L. Effect of crosslinking in chitosan/aloe vera-based membranes for biomedical applications. Carbohydr. Polym. 2013, 98, 581–588. [Google Scholar] [CrossRef] [PubMed]
- Fani, M.; Kohanteb, J. Inhibitory activity of Aloe vera gel on some clinically isolated cariogenic and periodontopathic bacteria. J. Oral Sci. 2012, 54, 15–21. [Google Scholar] [CrossRef] [PubMed]
- Agnes Mary, S.; Giri Dev, V.R. Electrospun herbal nanofibrous wound dressings for skin tissue engineering. J. Text. Inst. 2015, 106, 886–895. [Google Scholar] [CrossRef]
- Suganya, S.; Venugopal, J.; Agnes Mary, S.; Ramakrishna, S.; Lakshmi, B.S.; Giri Dev, V.R. Aloe vera incorporated biomimetic nanofibrous scaffold: A regenerative approach for skin tissue engineering. Iran. Polym. J. 2014, 23, 237–248. [Google Scholar] [CrossRef]
- Sridhar, R.; Ravanan, S.; Venugopal, J.R.; Sundarrajan, S.; Pliszka, D.; Sivasubramanian, S.; Gunasekaran, P.; Prabhakaran, M.; Madhaiyan, K.; Sahayaraj, A.; et al. Curcumin- and natural extract-loaded nanofibres for potential treatment of lung and breast cancer: In vitro efficacy evaluation. J. Biomater. Sci. Polym. Ed. 2014, 25, 985–998. [Google Scholar] [CrossRef]
- Abdullah, N.A.; Sekak, K.A.; Ahmad, M.R.; Effendi, T.B. Characteristics of Electrospun PVA-Aloe vera Nanofibres Produced via Electrospinning. In Proceedings of the International Colloquium in Textile Engineering, Fashion, Apparel and Design 2014 (ICTEFAD 2014), Penang, Malaysian, 7–8 April 2014; pp. 7–11. [Google Scholar]
- Isfahani, F.R.; Tavanai, H.; Morshed, M. Release of aloe vera from electrospun aloe vera-PVA nanofibrous pad. Fibers Polym. 2017, 18, 264–271. [Google Scholar] [CrossRef]
- Selvi, B.T.; Rajendren, R.; Nithyalakshmi, B.; Gayathirignaneswari, S. Antimicrobial activity of cotton fabric treated with Aloevera extract. Int. J. Appl. Environ. Sci. 2011, 6, 127–131. [Google Scholar]
- Ahmad, M.R.; Yahya, M.F. Proceedings of the International Colloquium in Textile Engineering, Fashion, Apparel and Design 2014 (ICTEFAD 2014); Springer: Singapore, 2014. [Google Scholar]
- Uslu, I.; Keskin, S.; Gül, A.; Karabulut, T.C.; Aksu, M.L. Preparation and properties of electrospun poly (vinyl alcohol) blended hybrid polymer with aloe vera and HPMC as wound dressing. Hacet. J. Biol. Chem. 2010, 38, 19–25. [Google Scholar]
- Uslu, I.; Aytimur, A. Production and characterization of poly(vinyl alcohol)/poly(vinylpyrrolidone) iodine/poly(ethylene glycol) electrospun fibers with (hydroxypropyl)methyl cellulose and aloe vera as promising material for wound dressing. J. Appl. Polym. Sci. 2012, 124, 3520–3524. [Google Scholar] [CrossRef]
- Hamman, J.H. Composition and applications of Aloe vera leaf gel. Molecules 2008, 13, 1599–1616. [Google Scholar] [CrossRef]
- Pawar, V.C.; Bagatharia, S.B.; Thaker, V.S. Antibacterial activity of Aloe vera leaf gel extracts against Staphylococcus aureus. Indian J. Microbiol. 2005, 45, 227–229. [Google Scholar]
- Lawrence, R.; Tripathi, P.; Jeyakumar, E. Isolation, purification and evaluation of antibacterial agents from Aloe Vera. Braz. J. Microbiol. 2009, 40, 906–915. [Google Scholar] [CrossRef] [PubMed]

© 2020 by the authors. Licensee MDPI, Basel, Switzerland. This article is an open access article distributed under the terms and conditions of the Creative Commons Attribution (CC BY) license (http://creativecommons.org/licenses/by/4.0/).
Share and Cite
Khanzada, H.; Salam, A.; Qadir, M.B.; Phan, D.-N.; Hassan, T.; Munir, M.U.; Pasha, K.; Hassan, N.; Khan, M.Q.; Kim, I.S. Fabrication of Promising Antimicrobial Aloe Vera/PVA Electrospun Nanofibers for Protective Clothing. Materials 2020, 13, 3884. https://doi.org/10.3390/ma13173884
Khanzada H, Salam A, Qadir MB, Phan D-N, Hassan T, Munir MU, Pasha K, Hassan N, Khan MQ, Kim IS. Fabrication of Promising Antimicrobial Aloe Vera/PVA Electrospun Nanofibers for Protective Clothing. Materials. 2020; 13(17):3884. https://doi.org/10.3390/ma13173884
Chicago/Turabian StyleKhanzada, Haleema, Abdul Salam, Muhammad Bilal Qadir, Duy-Nam Phan, Tufail Hassan, Muhammad Usman Munir, Khalid Pasha, Nafees Hassan, Muhammad Qamar Khan, and Ick Soo Kim. 2020. "Fabrication of Promising Antimicrobial Aloe Vera/PVA Electrospun Nanofibers for Protective Clothing" Materials 13, no. 17: 3884. https://doi.org/10.3390/ma13173884
APA StyleKhanzada, H., Salam, A., Qadir, M. B., Phan, D.-N., Hassan, T., Munir, M. U., Pasha, K., Hassan, N., Khan, M. Q., & Kim, I. S. (2020). Fabrication of Promising Antimicrobial Aloe Vera/PVA Electrospun Nanofibers for Protective Clothing. Materials, 13(17), 3884. https://doi.org/10.3390/ma13173884






